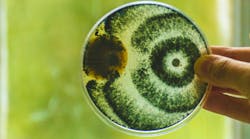
Content Dam Diq Online Articles 2018 09 Nagelberg39t Content Dam Diq Online Articles 2018 09 Nagelberg39t

We must stop focusing on bacteria and the body as separate entities. Consider this: "The goal of periodontal therapy is not to kill as many bacteria as possible, but, rather, to restore the delicate balance between the body and the microbiome." Dr. Richard Nagelberg takes a complex topic and breaks it down into understandable bites. This will positively affect how you view overall health and approach therapy for patients who have periodontal disease.
So, what is actually going on with us and the bugs that take up residence in and on our bodies? Are we merely tolerating them as long as they don’t do us any harm, or at least very little? Are we putting up with them because every now and then they provide some useful service? In the pursuit of health, is the goal to wipe out as many bugs as we can?
As it turns out, we are one with the microbiome in an arrangement called a holobiont, which is defined as an assemblage of different species that form an ecological unit. Another way to look at a holobiont is as the host plus all of its stable and transient microbial symbionts. Rather than existing as separate, distinct entities from our microbiome, we are both part of the holobiont. Microbes have been performing metabolic functions for all mammals and, presumably, all other animals for half a billion years. The bugs and hosts have coevolved over millions of years. (1)
The microbiome does not exist as separate single-celled organisms; rather, the microbiome forms highly regulated, structurally and functionally organized communities as biofilms. The body and the microbiome have a finely tuned equilibrium that maintains health. When this equilibrium is disturbed, disease development can occur. The goal of periodontal therapy is not to kill as many bacteria as possible, but, rather, to restore this delicate balance between the body and the microbiome.
Keep up with the latest in
oral-systemic research
Click HERE to access all of the articles in DentistryIQ's popular blog, "Making the Oral-Systemic Connection," by Dr. Richard H. Nagelberg. Click HERE to write to Dr. Nagelberg about any topics you've read about in this blog or to submit items you'd like to see covered here.
Does this make a difference for clinicians? It's too soon to tell, but it bears keeping in mind that this concept provides some insight into what is happening with our patients. When a patient takes the first tentative steps down the path of periodontal disease, we must realize that the balance between the microbes and the body is getting out of whack. In the absence of a systemic ailment that is compromising the patient's immune system, the most likely interpretation is that the delicate balance between the body and the microbiome is being disturbed by rising bacterial levels.
At this point, detailed examination of the patient’s home-care regimen should be undertaken, with recommendations to maximize restoration of the balance between body and microbiome. Considering the holobiont as one, however, would dictate that lifestyle recommendations to strengthen the host should be made. Rather than focusing on the bugs and the body as separate entities, we should consider them as one, realizing that maintaining the proper balance is the goal of therapy.
Reference
1. Kilian M, Chapple IL, Hannig M, et al. The oral microbiome—an update for oral healthcare professionals. Br Dent J. 2016;221(10):657-666. doi: 10.1038/sj.bdj.2016.865.
For more articles about clinical dentistry, click here.
For the most current dental headlines, click here.
About the Author
Richard H. Nagelberg, DDS
Richard H. Nagelberg, DDS, has practiced general dentistry in suburban Philadelphia for more than 30 years. He has served on many advisory boards and as a consultant and key opinion leader for a variety of companies and organizations. Dr. Nagelberg is the Director of Medical Affairs at OraPharma, a division of Bausch Health US, LLC. His practice and other professional activities are centered on the impact dental professionals have beyond the oral cavity. Contact Dr. Nagelberg at [email protected].
Updated May 2022